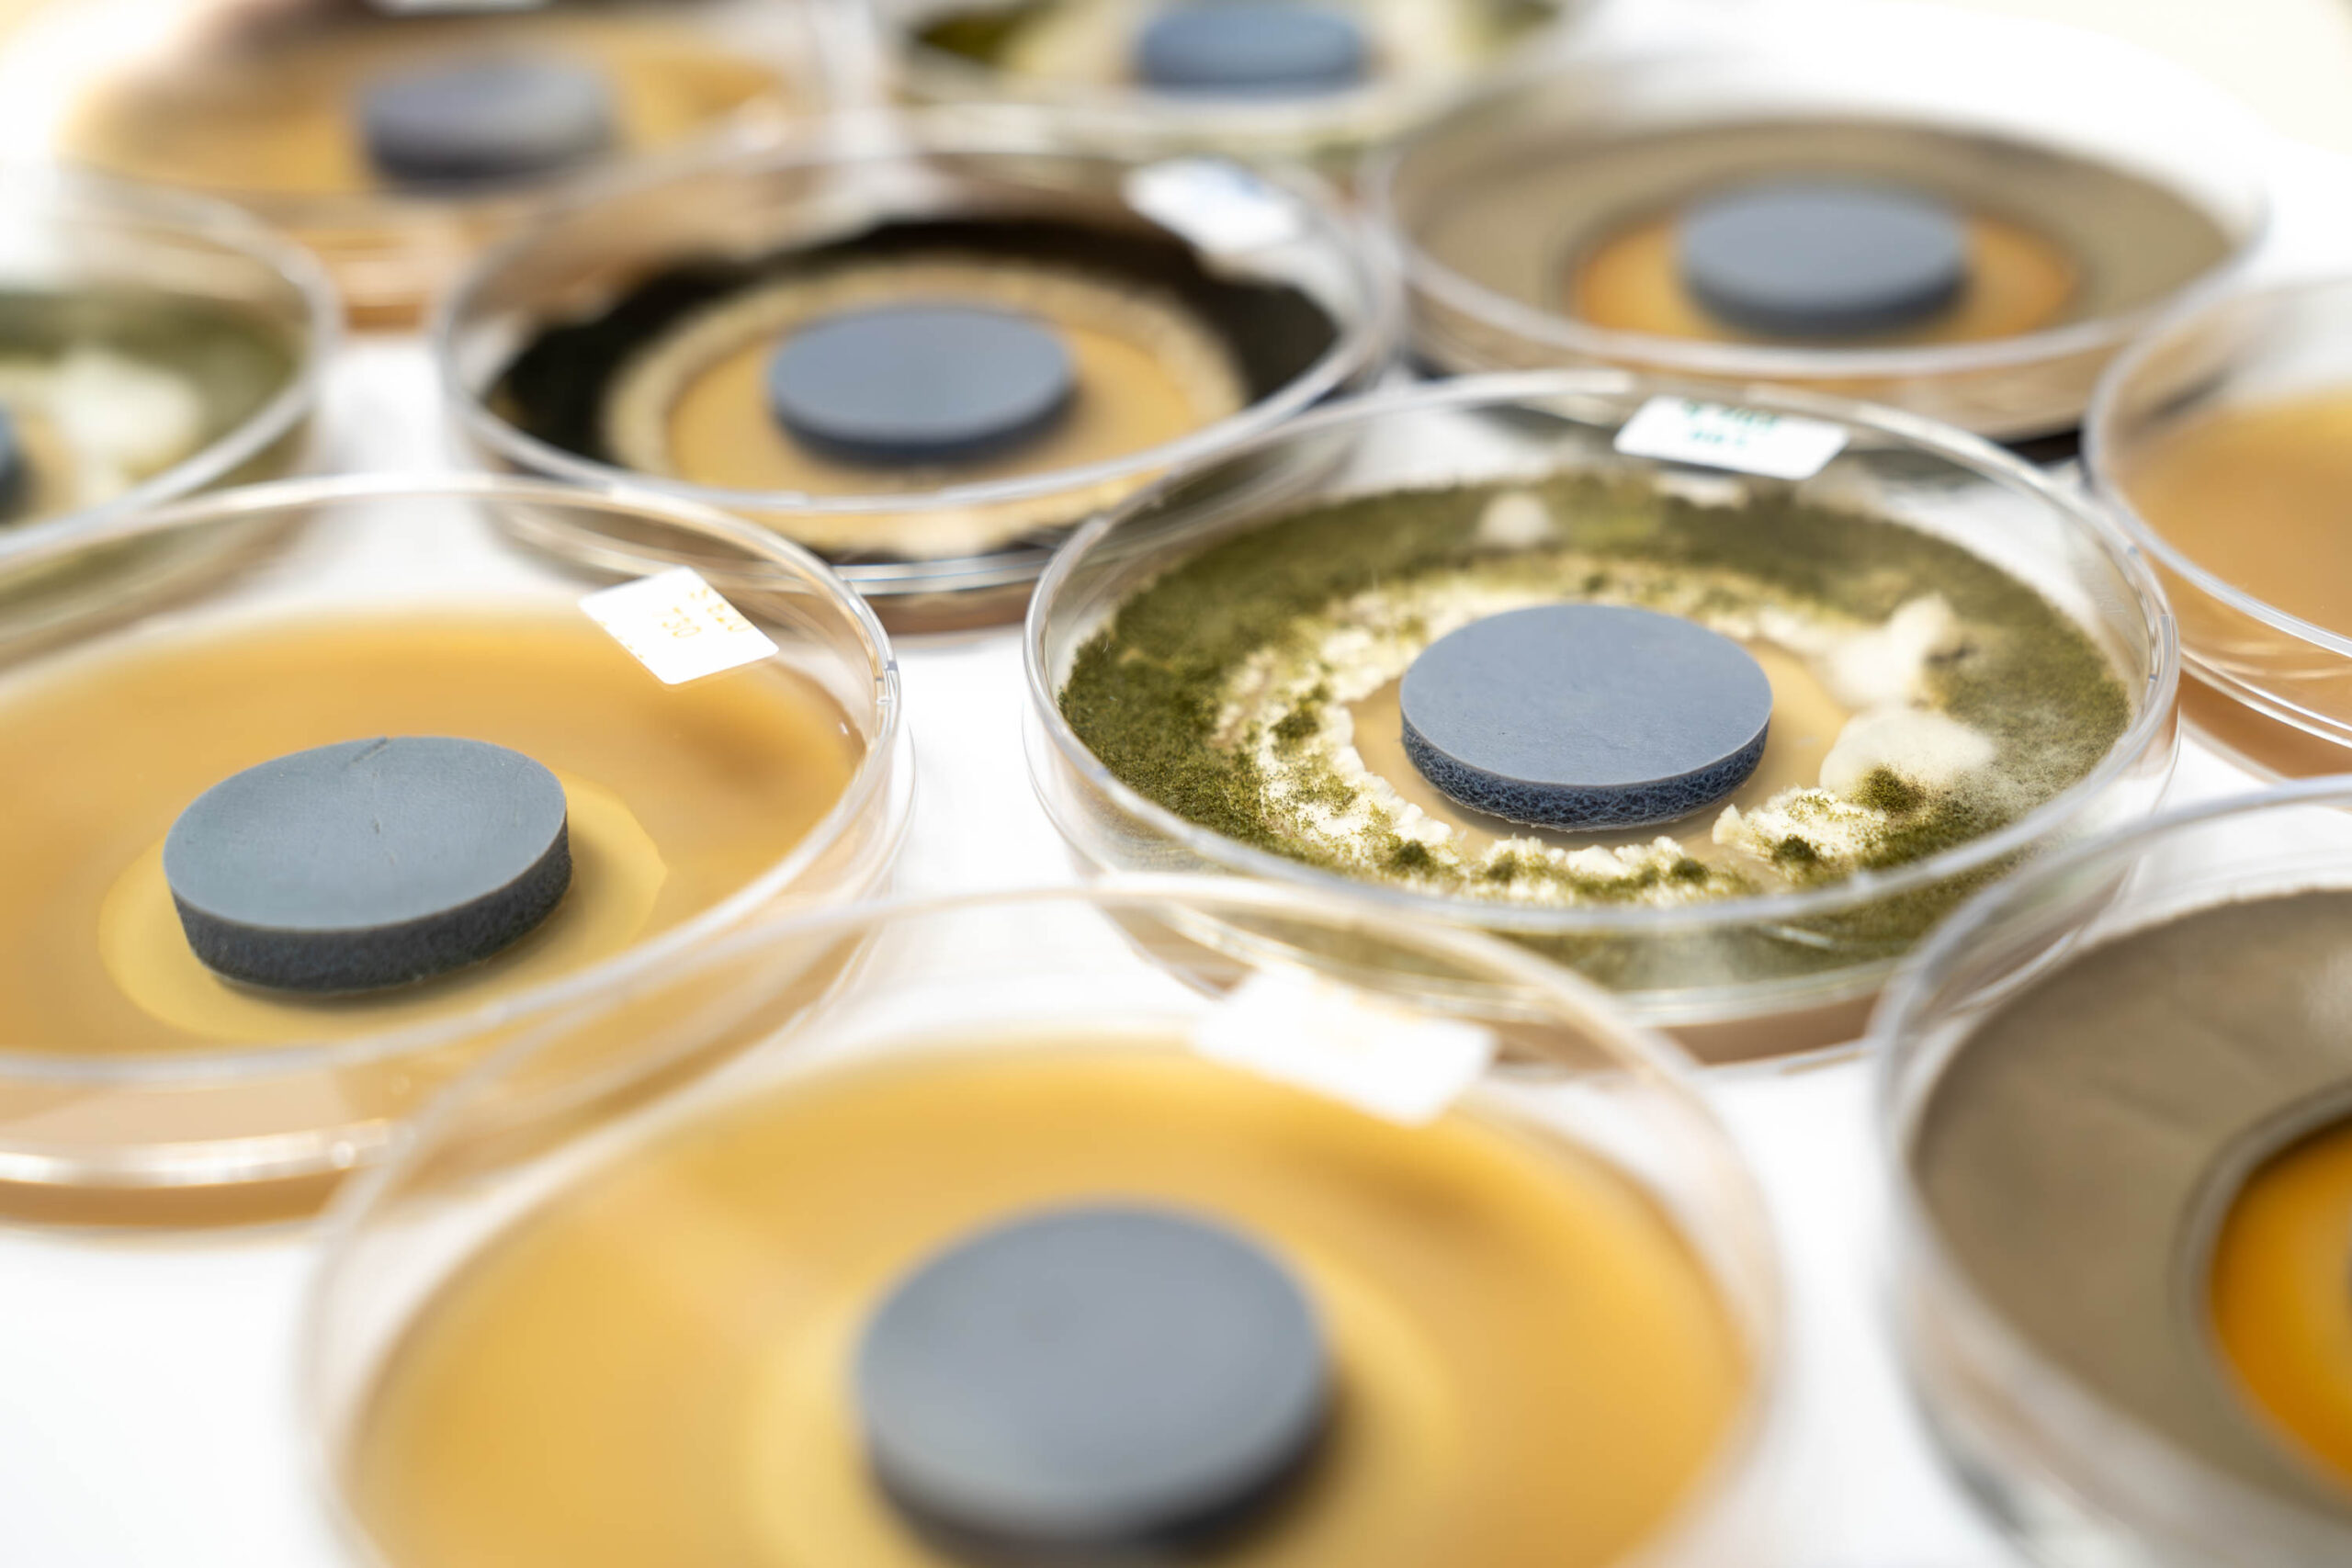

2025年2月11日

德國將在德國館展示尖端的可持續鞣革解決方案。這些產業領導者將帶來一系列滿足鞣革產業不斷變化需求的創新產品,讓您體驗技術進步的魅力。
精選制革方案供應商
LANXESS Deutschland GmbH
展位號碼: 3C-C34-DE

Energizing Chemistry是LANXESS的座右銘。他們致力於在皮革鞣製市場中快速回應客戶要求。在過去20年中,憑藉創新方法和適應能力不斷自我革新,成功應對各種挑戰。 LANXESS提供的不僅是化學產品 – 他們的永續方案解決了當今皮革鞣製中的緊迫問題,共同負起為對未來的責任。
照片由LANXESS Deutschland GmbH 提供
官方網站: https://lanxess.com/
Pulcra Chemicals GmbH
展位號碼: 3C-B34-DE

Pulcra Chemicals是一家國際公司,具備卓越的工程能力和獨特的工藝知識。他們累積了超過140年的經驗,為纖維、紡織和皮革產業生產創新的特殊化學品。 Pulcra Chemicals在16個國家設有生產設施、服務實驗室和銷售辦公室。他們的目標是使客戶成功,並盡一切可能在產品開發、法律合規和永續發展方面給予支持。

照片由Pulcra Chemicals GmbH提供
官方網站: www.pulcra-chemicals.com
Ungricht GmbH + Co. KG | Sauereissig Surfaces
展位號碼: 3C-B26-DE

數十年來,他們一直生產皮革和人造物料表面壓花設計的裝飾薄膜和工具,為家具、運動和汽車行業的客戶,還有國際時尚市場的知名製造商提供產品,開發的產品特別著重符合行業的高品質標準。他們熟悉高要求客戶提出的複雜工序,並以專業的服務和靈活的方式協助他們。
他們專門生產適合不同表面結構的壓花輥和壓花板,並提供設計集合,其中包含超過80,000個壓花和50,000個印刷設計。

照片由Ungricht GmbH + Co. KG提供
Volpker Spezialprodukte GmbH
展位號碼: 3C-C32-DE
Voelpker Spezialprodukte GmbH成立於1900年,是特種蠟製造商。在1970年代,Voelpker發現了以重鉻酸鈉作為氧化劑的高效技術, 因而能夠為皮革產業生產鹼式硫酸鉻。 VOELPKER的硫酸鉻鞣劑以BASOCHROM® 33作為商標,並已發佈在ZDHC(有害化學物質零排放)Gateway線上平台,代表產品符合生產限用物質清單(MRSL)的標準。
來自德國的Voelpker Spezialprodukte GmbH也是皮革工作小組(LWG)的成員,目前獲得EcoVadis 銀級認證。 Voelpker的硫酸鉻以Basochrom作為商標,並獲得德國皮爾馬森斯測試研究所(PFI)認證,可用於生產低污染皮革(「SG標誌」)。

照片由Volpker Spezialprodukte GmbH提供
以下是德國館的更多參展商:
